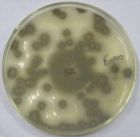
黴菌

簡介
 薩克斯肺
薩克斯肺,是因使用滋生黴菌的薩克斯管而引發的肺部感染。一些薩克斯樂手,由於長時間不清洗自己的薩克斯,導致樂器內部滋生大量黴菌。一旦演奏該薩克斯,黴菌進入演奏者的肺部,就會產生過敏反應,甚至引發嚴重的肺部炎症、肺壞疽。
病理生理
黴菌
黴菌引發肺部感染的黴菌種類主要有麴黴菌,組織孢漿菌、隱球菌、芽生菌、球孢子留、諾卡氏菌等。這些黴菌的孢子在潮濕的環境下很快發育,其進度的溫度為37~40℃,因此在自然界中分布較廣,當薩克斯手演奏滋生了黴菌的薩克斯管時,黴菌及霉孢子侵入呼吸道後,在呼吸道黏膜發育的同時,引起局部炎症反應。在肺臟形成大小不等的結節,在小結節個心有化膿灶。其中含有黴菌絲,周圍有結締組織包膜。有的在支氣管黏膜形成潰瘍。急性經過時,多呈異物性肺炎的病徵,並繼發肺壞疽。
檢查診斷
X片可見肺內黴菌感染病灶;取病灶組織少許,置載玻片上,加生理鹽水1~2滴,用細針將組織搗碎,在顯微鏡下觀查,如見菌絲和孢子,即可確診。
臨床表現
具有支氣管肺炎的症狀,從鼻孔流出污穢的鼻液。顯微鏡檢查可見黴菌的菌絲。黏膜蒼白或發紺,肺部可聽到羅音。呼吸困難,日漸消瘦,並伴有角膜混濁或潰瘍。
防治方法
黴菌能在樂器里生存數小時甚至數天,建議用家定期清潔樂器。
積極控制感染,保持呼吸道通暢、糾正缺氧,防治併發症,增強機體抵抗力以促進康復。
肺部已經感染黴菌的患者,要遵照醫囑,進行藥物治療。
病例
2013年,美國亞特蘭大一名68歲的管樂演奏者患上薩克斯肺已有一年時間,原因是他已有30年都沒有清洗過自己的樂器――薩克斯。這名老樂手照X光時,發現肺內已全是黴菌。其後,他按照醫生指示服藥,並清潔薩克斯後,病情實時好轉。

